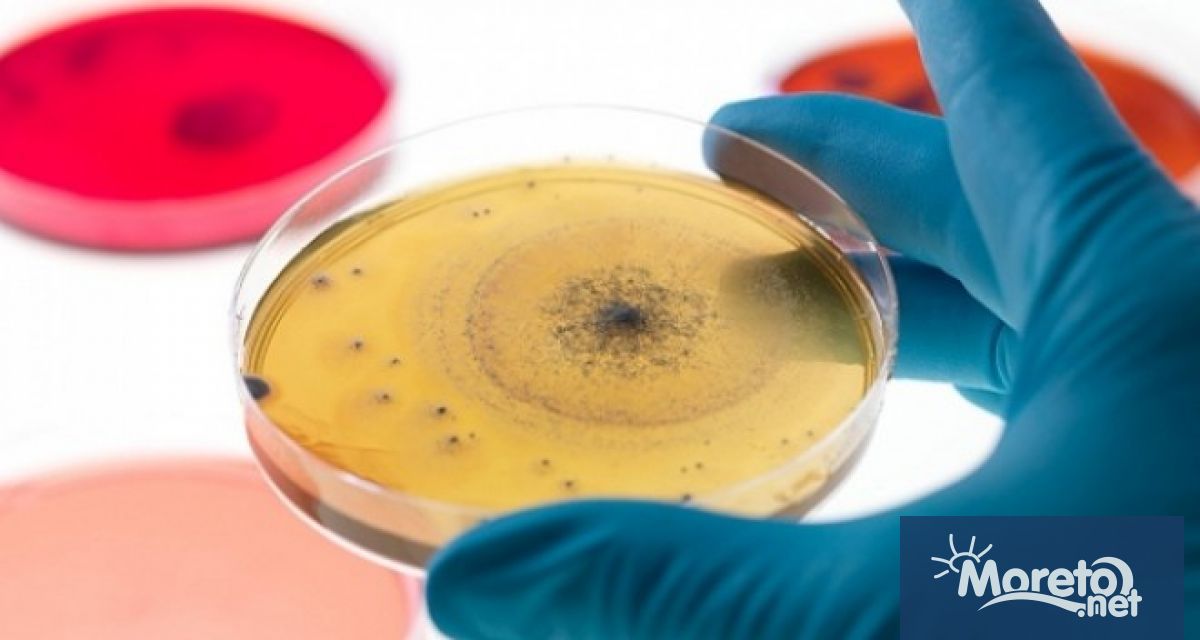
На 28 юли се отбелязва Световния ден за борба с

... но могат да имат сериозни последици при късна диагностика. Присъединете се към нашия Работодатели могат да получат до 20 000 лв. за наемане на хора с увреждания
Хепатита - Новини
Община в партньорство с Регионалната здравна инспекция – и
...... г. Световната здравна организация изчислява, че над 350 милиона души по света живеят с вирусен хепатит, като 9 от 10 не знаят, че са носители.
Двойно увеличение на хепатита у нас – експертите притеснениПлашещо е
...... чисто, защото има голям приток на сладка вода от Дунав и Днепър, а този микс със солена вода го прави много приятно е за къпане.
На 28 юли светът отбелязва Световния ден за борба с
...... за информираност, но и призив за действия към постигане на глобалната цел за елиминиране на вирусния хепатит до 2030 година, заложена от Световната здравна организация.
Половин милион души в България са заразени без да знаят
...... да се лекуват. Половин милион души в България имат хепатит, без да знаят. Годишно само 1000 души с хепатит С у нас се подлагат на лечение..
Според статистиката всеки дванадесети човек по света е носител на
...... на игли при наркозависими, стоматологични интервенции, татуиране, акупунктура, хемодиализа, в редки случаи и при полов контакт (около 1%). По света има над 170 милиона болни.
Световният ден за борба с хепатитасе отбелязва от 2006 година
...... на игли при наркозависими, стоматологични интервенции, татуиране, акупунктура, хемодиализа, в редки случаи и при полов контакт (около 1%). По света има над 170 милиона болни.
На 28 юли се отбелязва Световния ден за борба с
...... се лекуват. Половин милион души в България имат хепатит, без да знаят. Годишно само 1000 души с хепатит С у нас се подлагат на лечение.
Световният ден за борба с хепатита се отбелязва всяка година
...... срещат по-често в райони с лоши санитарни условия. Според експертите, ранната диагностика и ваксинацията срещу хепатит В и А са сред най-ефективните мерки за превенция.
Световният ден за борба с хепатита се отбелязва всяка година
...... се срещат по-често в райони с лоши санитарни условия. Според експертите, ранната диагностика и ваксинацията срещу хепатит В и А са сред най-ефективните мерки за превенция.
19 ти май е Световният ден за борба с хепатита койтосе
...... 350 милиона хронично болни. Приблизително 70% от инфектираните с вируса на хепатит С развиватхроничен хепатит C.По света има повече от 170 милиона болни от хепатит.
По случай 28 юли Световен ден за борба с хепатита
...... важна за спиране на увреждането на черния дроб, както и за ограничаване разпространението на инфекцията. Хепатит С се лекува успешно в рамките на 8-12 седмици.
Всяка година на 28 юли Световна здравна организация отбелязва Световния
...... на светлина, нарушава се дишането, понижава се артериалното кръвно налягане. Изходът в голям процент от случаите е летален. Д-р Таня Перчемлиева - директор на дирекция НЗБ
В Плевен ще се състои кампания за безплатни изследвания за
...... за пореден път се поставя акцент върху неотложността на действията и усилията, необходими за премахване на хепатита като заплаха за общественото здраве до 2030 г.
На 28 юли отбелязваме когато е и рожденият ден
...... дроб медикаменти, от диетата се изключват консервирани меса и риба, пикантни подправки, пържена храна и други. Благотворително събитие в Бургас: „Кино на открито за малкия Алекс“
С различни инициативи в страната ще бъде отбелязан Световният ден
...... за пореден път се поставя акцент върху неотложността на действията и усилията, необходими за премахване на хепатита като заплаха за общественото здраве до 2030 г.
На 28 юли се отбелязва Световния ден за борба с
...... се лекуват. Половин милион души в България имат хепатит, без да знаят. Годишно само 1000 души с хепатит С у нас се подлагат на лечение.
Световният ден за борба с хепатитасе отбелязва от 2006 година
...... на игли при наркозависими, стоматологични интервенции, татуиране, акупунктура, хемодиализа, в редки случаи и при полов контакт (около 1%). По света има над 170 милиона болни.
Отбелязваме Световния ден за борба с хепатита Денят се отбелязва
...... С. Те ще се организират с подкрепата на „Националната програма за превенция и контрол на вирусни хепатити в Република България 2021-2025 г.", съобщиха здравните власти.
Световният ден за борба с хепатита се отбелязва всяка година на
...... хепатити, който да подпомага Министерството на здравеопазването при осъществяване на превенцията и контрола, епидемиологичния надзор, диагностиката, лечението и медицинските грижи в областта на вирусните хепатити.
Отбелязваме Световния ден за борба с хепатита Денят се отбелязва от
...... С. Те ще се организират с подкрепата на „Националната програма за превенция и контрол на вирусни хепатити в Република България 2021-2025 г.“, съобщиха здравните власти.
Отбелязваме Световния ден за борба с хепатита Денят се отбелязва от
...... С. Те ще се организират с подкрепата на „Националната програма за превенция и контрол на вирусни хепатити в Република България 2021-2025 г.“, съобщиха здравните власти.
Световният ден за борба с хепатита се отбелязва всяка година
...... хепатити, който да подпомага Министерството на здравеопазването при осъществяване на превенцията и контрола, епидемиологичния надзор, диагностиката, лечението и медицинските грижи в областта на вирусните хепатити.
Всяка година Световният ден за борба с хепатита се отбелязва
...... Тези инфекции обаче рядко могат да бъдат тежки и животозастрашаващи поради риска от чернодробна недостатъчност. Бъдете отговорни по време на Световния ден за борба с хепатита!
Бургас ще отбележи Световния ден за борба с хепатита –
...... и да се възползвате от безплатни и анонимни изследвания за хепатит В и хепатит С. Психиатърът д-р Петър Стоев: Не психичноболните, а примитивните хора причиняват пожари
19 ти май е Световният ден за борба с хепатита Той
...... стоматологични интервенции, татуиране, акупунктура, хемодиализа, в редки случаи и при полов контакт - около 1%. По света има повече от 170 милиона болни от хепатит.
Световният ден за борба с хепатитасе отбелязва от 2006 година
...... на игли при наркозависими, стоматологични интервенции, татуиране, акупунктура, хемодиализа, в редки случаи и при полов контакт (около 1%). По света има над 170 милиона болни.
Световният ден за борба с хепатита се провежда всяка година
...... , който да подпомага Министерството на здравеопазването при осъществяване на превенцията и контрола, епидемиологичния надзор, диагностиката, лечението и медицинските грижи в областта на вирусните хепатити.
Световният ден за борба с хепатита се провежда всяка година
...... хепатити, който да подпомага Министерството на здравеопазването при осъществяване на превенцията и контрола, епидемиологичния надзор, диагностиката, лечението и медицинските грижи в областта на вирусните хепатити.
На 28 юли се отбелязва Световния ден за борба с
...... се лекуват. Половин милион души в България имат хепатит, без да знаят. Годишно само 1000 души с хепатит С у нас се подлагат на лечение.
Световният ден за борба с хепатита се провежда всяка година
...... хепатити, който да подпомага Министерството на здравеопазването при осъществяване на превенцията и контрола, епидемиологичния надзор, диагностиката, лечението и медицинските грижи в областта на вирусните хепатити.
Вирусните хепатити са най различни като най сериозните от тях са хепатит
...... 1,5 млн. нови случаи на хепатит В и С. За 2019 г. смъртните случаи са 820 000 от хепатит В и 290 000 – от хепатит С.
По случай 28 юли Световен ден за борба с хепатита
...... сериозни чернодробни проблеми, включително рак. Затова РЗИ – Смолян призовава да се изследваме и узнаем навреме своя статус за носителство на хепатити В и С.
Световният ден за борба с хепатита се провежда всяка година
...... 2023 г. от 10 – 12 часа). За насърчаване на ранна диагностика на хепатит В и С е създаден и Viber канал "Веднъж в живота".
Световният ден за борба с хепатита се провежда всяка година
...... Габрово можете да намерите QR код, за публичния вайбър канал с името „Веднъж в живота“, чрез който можете да получите информация за вирусните хепатит ВиС.
hepatit Thinkstock Getty Images19 май е Световният ден за борба
...... стоматологични интервенции, татуиране, акупунктура, хемодиализа, в редки случаи и при полов контакт - около 1%. По света има повече от 170 милиона болни от хепатит.
На 28 юли се отбелязва Световния ден за борба с
...... се лекуват. Половин милион души в България имат хепатит, без да знаят. Годишно само 1000 души с хепатит С у нас се подлагат на лечение.
Маймунската шарка се регистрира във все повече страни по света
...... и да уведоми РЗИ“, каза Кантарджиев. Според професора причината тези заболявания да се разпространяват в момента е, че хората започнаха да пътуват повече след коронавируса и не се пазят.
Има конкретни мерки които родителите биха могли да вземат за
...... си носят маските на местата, където има струпване на хора. Който не се е ваксинирал, да го направи до края на лятото”, призова проф. Кантарджиев.
Има конкретни мерки които родителите биха могли да вземат за
...... си носят маските на местата, където има струпване на хора. Който не се е ваксинирал, да го направи до края на лятото”, призова проф. Кантарджиев.
Има конкретни мерки които родителите биха могли да вземат за
...... си носят маските на местата, където има струпване на хора. Който не се е ваксинирал, да го направи до края на лятото”, призова проф. Кантарджиев.
Има конкретни мерки които родителите биха могли да вземат за да
...... си носят маските на местата, където има струпване на хора. Който не се е ваксинирал, да го направи до края на лятото", призова проф. Кантарджиев.
Има конкретни мерки които родителите биха могли да вземат за
...... местата, където има струпване на хора. Който не се е ваксинирал, да го направи до края на лятото”, призова проф. Кантарджиев.Целия разговор гледайте във видеото.
Има конкретни мерки които родителите биха могли да вземат за
...... си носят маските на местата, където има струпване на хора. Който не се е ваксинирал, да го направи до края на лятото“, призова проф. Кантарджиев.
Има конкретни мерки които родителите биха могли да вземат за
...... местата, където има струпване на хора. Който не се е ваксинирал, да го направи до края на лятото”, призова проф. Кантарджиев.Целия разговор гледайте във видеото.
Има конкретни мерки които родителите биха могли да вземат за
...... си носят маските на местата, където има струпване на хора. Който не се е ваксинирал, да го направи до края на лятото“, призова проф. Кантарджиев.
Има конкретни мерки които родителите биха могли да вземат за
...... си носят маските на местата, където има струпване на хора. Който не се е ваксинирал, да го направи до края на лятото”, призова проф. Кантарджиев.
Има конкретни мерки които родителите биха могли да вземат за
...... си носят маските на местата, където има струпване на хора. Който не се е ваксинирал, да го направи до края на лятото”, призова проф. Кантарджиев.
Има конкретни мерки които родителите биха могли да вземат за
...... си носят маските на местата, където има струпване на хора. Който не се е ваксинирал, да го направи до края на лятото”, призова проф. Кантарджиев.


)